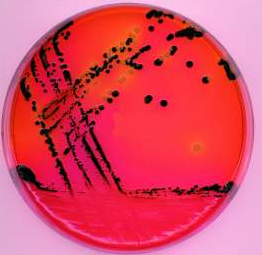
伊红美蓝培养基（EMB）

伊红美蓝培养基(EMB)
Eosin blue medium (EMB)
询价
250g
起订
北京 更新日期:2026-04-21
产品详情:
- 中文名称:
- 伊红美蓝培养基(EMB)
- 英文名称:
- Eosin blue medium (EMB)
- 产品类别:
- 培养基
公司简介
北京北纳创联生物技术研究院,是一家专业从事微生物工程、生物化学领域技术研发、以及化学计量分析仪器研发的科研单位。 标准物质事业部及其香港分部——香港华美技术有限公司,依托以香港为中心的技术力量和采购渠道,代理销售国内外数万种标准物质和标准样品,凭借强大的分析测试、技术开发、物流管理和售后服务能力,成为多家国内外知名标准物质研制单位和分析仪器公司的代理商。
| 成立日期 | (16年) |
| 注册资本 | 350万人民币 |
| 员工人数 | 10-50人 |
| 年营业额 | ¥ 100万-300万 |
| 经营模式 | 定制 |
| 主营行业 | 标准品和对照品,细胞培养 |
伊红美蓝培养基(EMB)相关厂家报价 更多
-

- 水溶伊红
- 开原市沈新精细化工厂 VIP
- 2026-04-22
- ¥320.00
-

- 伊红美蓝琼脂(EMB)
- 北京索莱宝科技有限公司 VIP
- 2026-04-22
- ¥270.00
-

- 伊文思蓝
- 河南威梯希化工科技有限公司 VIP
- 2026-04-22
- 询价